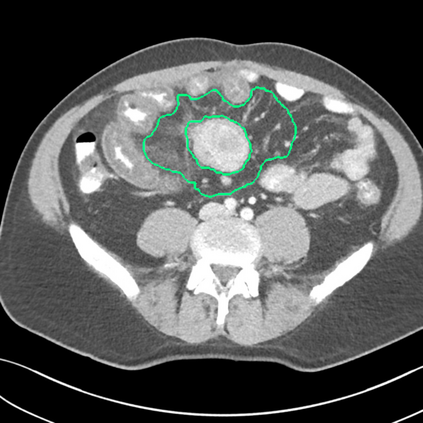

Radiomics uses quantitative medical imaging features to predict clinical outcomes. Currently, in a new clinical application, finding the optimal radiomics method out of the wide range of available options has to be done manually through a heuristic trial-and-error process. In this study we propose a framework for automatically optimizing the construction of radiomics workflows per application. To this end, we formulate radiomics as a modular workflow and include a large collection of common algorithms for each component. To optimize the workflow per application, we employ automated machine learning using a random search and ensembling. We evaluate our method in twelve different clinical applications, resulting in the following area under the curves: 1) liposarcoma (0.83); 2) desmoid-type fibromatosis (0.82); 3) primary liver tumors (0.80); 4) gastrointestinal stromal tumors (0.77); 5) colorectal liver metastases (0.61); 6) melanoma metastases (0.45); 7) hepatocellular carcinoma (0.75); 8) mesenteric fibrosis (0.80); 9) prostate cancer (0.72); 10) glioma (0.71); 11) Alzheimer's disease (0.87); and 12) head and neck cancer (0.84). We show that our framework has a competitive performance compared human experts, outperforms a radiomics baseline, and performs similar or superior to Bayesian optimization and more advanced ensemble approaches. Concluding, our method fully automatically optimizes the construction of radiomics workflows, thereby streamlining the search for radiomics biomarkers in new applications. To facilitate reproducibility and future research, we publicly release six datasets, the software implementation of our framework, and the code to reproduce this study.
翻译:放射科使用定量医学成像特征来预测临床结果。目前,在一个新的临床应用中,通过一个超常试验和高压过程,通过人工操作,从广泛的现有选项中找到最佳放射法。在本研究中,我们提议了一个框架,自动优化每个应用程序的放射工作流程的建设。为此,我们将放射作为模块工作流程,并包括每个部件的大量通用算法。为了优化每个应用程序的工作流程,我们使用随机搜索和聚合的自动机学习方法。我们用12种不同的临床应用来评估我们的方法,结果在曲线下应用的以下领域:1) 脂色瘤(0.83);2) 脱氧型纤维瘤(0.82);3 初级肝脏肿瘤(0.80);4 气肠肿瘤(0.77)、5 彩虹肝脏移植(0.61); 6 脑膜细胞变异常(0.45); 7) 肝细胞变异常(0.8) 脑纤维变异位(0.80); 9) 直径直线型癌症(0.74) 和头型癌症(0.77) 直径研究(10) 。